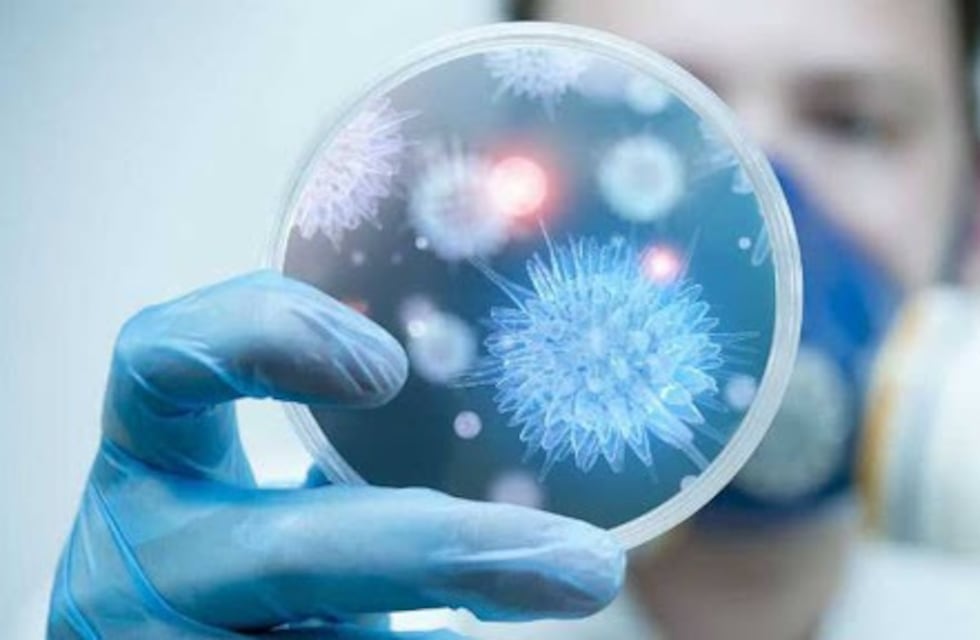

El Gobierno de Mendoza, a través del Ministerio de Salud, Desarrollo Social y Deportes, informa las cantidades de personas positivas, recuperadas y fallecidas por Covid-19. También se comunican las cantidades de PCR y test de antígenos realizados en las últimas 24 horas.
//Mirá También: Mayores de 40 con obesidad ya pueden inscribirse para la vacuna en Mendoza
Los datos se desprenden del Sistema Integrado de Información Sanitaria Argentina (SISA), los cuales son proporcionados por los hospitales, centros de salud y establecimientos de aislamiento extrahospitalarios de la provincia. Se informa la recuperación de 801 pacientes con Covid-19.
Asimismo, la Red de Laboratorios del Ministerio de Salud, Desarrollo Social y Deportes de la Provincia informó que entre las últimas horas de ayer y hoy se procesaron 3.019 determinaciones:
2.195 fueron negativas.
824 nuevos casos positivos.
En cuanto a la cantidad de fallecidos, se reportaron:
13 en las últimas 48 horas.
9 según la carga en SISA, reportados con fechas anteriores.
La provincia de Mendoza registra al día de hoy:
90.881 casos positivos confirmados Covid-19.
86.848 personas recuperadas Covid-19.
1.825 fallecimientos por Covid-19.
//Mirá también: Docentes conocerán en tiempo real los contagios en las escuelas mendocinas
Es importante recordar que el Ministerio de Salud de Mendoza informa a todos los pacientes que ingresan al sistema sanitario público y privado de la provincia. En caso de que un mendocino dé positivo en otras jurisdicciones nacionales –por estar estudiando en otra provincia, por vivir en otro lugar sin registrar el cambio de domicilio o por estar realizando un trabajo temporario–, no será registrado como caso confirmado en Mendoza. Fuente Gobierno de Mendoza